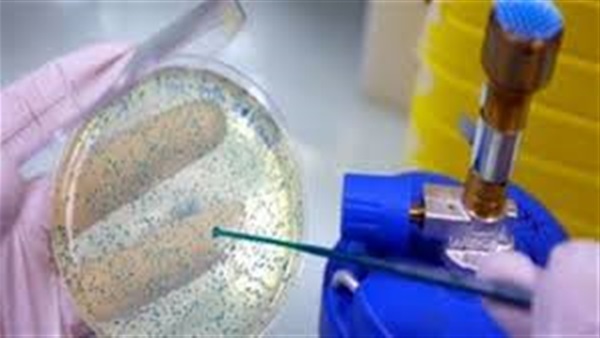
علماء صينيون يكتشفون مادة أقوى من الفولاذ وخفيفة كالبالونة تصلح للاستخدامات العسكرية

علماء صينيون يكتشفون مادة أقوى من الفولاذ وخفيفة كالبالونة تصلح للاستخدامات العسكرية
الأربعاء، 21 سبتمبر 2016 08:36 ص
اكتشف العلماء الصينيون مادة سوبر تتميز بأنها خفيفة مثل البالونة ولكنها تتمتع بقوة المعدن حيث يفكرون حاليا فى تطويرها لتصلح للاستخدام العسكري.
وقد كشفت صحيفة "ساوث تشاينا مورنينج بوست" ان المادة الشبيهة بالرغوة مكونة من أنابيب صغيرة من الجرافين متراصة في بنية خلوية تشبه فى استقرار هيكلها التكوين الخاص بالألماس.
وطبقا لدراسة أجراها باحثون في معهد شنغهاي للسيراميك التابع للأكاديمية الصينية للعلوم فتلك المادة تعد أقوى من الفولاذ 207 مرات ويمكنها أن تتحمل وزنا أكبر من وزنها بنحو 40 ألف مرة بدون أن تنثنى.
كما تتميز المادة الجديدة تلك بمرونة عالية تمكنها من ان تتقلص إلى 5 في المائة فقط من حجمها الأصلي وان تستعيد شكلها الأصلى بعد ذلك.
وكما تشير الدراسة فإن تلك المادة يمكن استخدامها كبطانة للسترات الواقية من الرصاص أو فى الدروع الممتصة للصدمات الخاصة بالدبابات.





